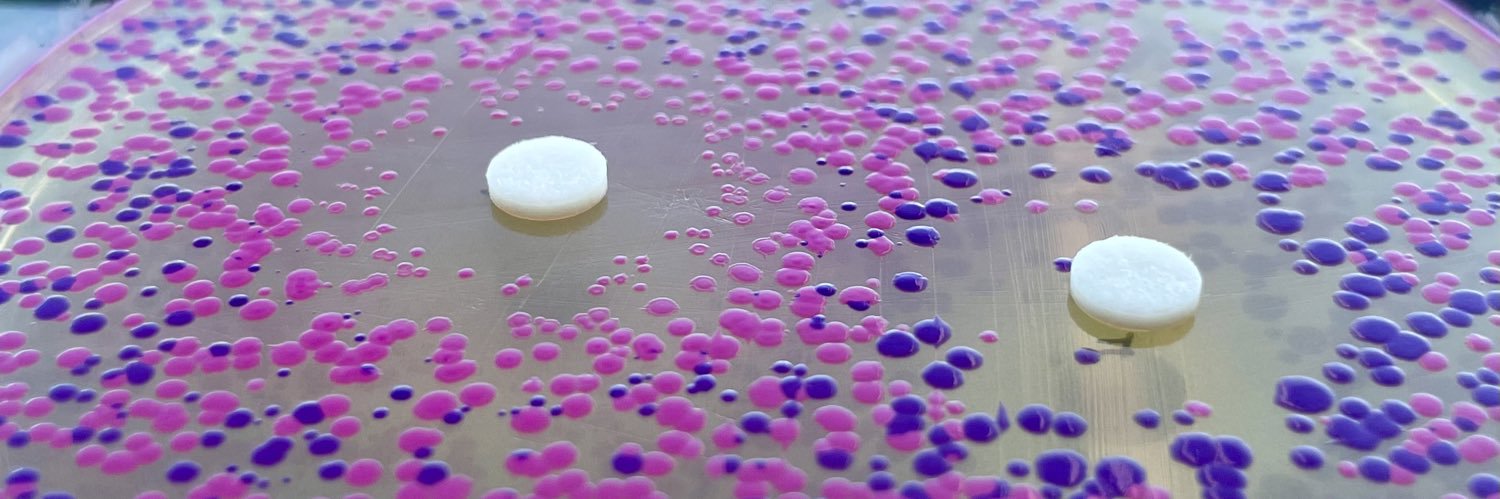
Mitchell Lab banner

Sabitlenmiş Tweet

Why are some non-antibiotic drugs toxic to bacteria 💊☠️🦠? Do they work like standard #antibiotics (ABX)? Our latest work by @MarianaNoto published @ScienceMagazine addresses this fundamental question (1/n)
science.org/doi/10.1126/sc…
English